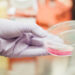
Legalidade da coleta obrigatória de DNA de condenados é confirmada pelo STJ

O STJ reafirma a tutela da liberdade sexual no crime de estupro, destacando que o consentimento inicial da vítima não exclui a tipicidade do delito se, no curso do ato sexual, houver discordância expressa e o agente persistir na conduta mediante violência ou grave ameaça.
Em outras palavras, para a caracterização do crime de estupro, o consentimento inicial da vítima não exclui a tipicidade do delito se, no decorrer da relação sexual, houver uma manifestação expressa de discordância, especialmente se o agressor prossegue utilizando violência para forçar a continuidade do ato.
No caso concreto, a vítima, embora inicialmente tenha consentido com a relação, manifestou expressa recusa em continuar. Isso porque a ausência de uma resistência física intensa por parte da vítima não desqualifica o crime, uma vez que a passividade subsequente pode ser uma reação natural diante da violência e do entendimento de que a resistência ativa seria ineficaz para evitar a continuidade do ato.
O réu, desconsiderando o dissenso reiterado, utilizou força física para consumar o ato, configurando o crime previsto no art. 213 do Código Penal.
O STJ ainda enfatiza que não se exige resistência física enérgica ou heroica da vítima para a caracterização do estupro. O dissenso claro e a utilização de violência são suficientes, sendo irrelevante a passividade ou submissão da vítima diante da percepção da impossibilidade de interromper o ato. Ademais, a Corte reforça o valor probante do depoimento da vítima em crimes sexuais, especialmente quando corroborado por outros relatos semelhantes, afastando a exigência de testemunhas presenciais para a comprovação do crime.
Além disso, o STJ ressalta que o fato de a vítima, eventualmente, ter se submetido ao ato na esperança de que ele terminasse logo não afasta o caráter violento do crime. A Corte argumenta que a complexidade das relações humanas e as respostas psicológicas das vítimas de violência sexual não podem ser simplificadas a ponto de excluir a prática do crime com base em comportamentos posteriores, como trocas de mensagens ou a cessação de resistência, que podem estar ligados a mecanismos de autoproteção diante da brutalidade sofrida.
O STJ reforça que, em crimes sexuais, o depoimento da vítima possui especial relevância, sobretudo quando corroborado por outros relatos de ofendidas que passaram por situações semelhantes.
Processo em segredo de justiça, Rel. Ministro Jesuíno Rissato (Desembargador convocado do TJDFT), Rel. para acórdão Ministro Sebastião Reis Júnior, Sexta Turma, por maioria, julgado em 13/08/2024, DJe 16/08/2024.